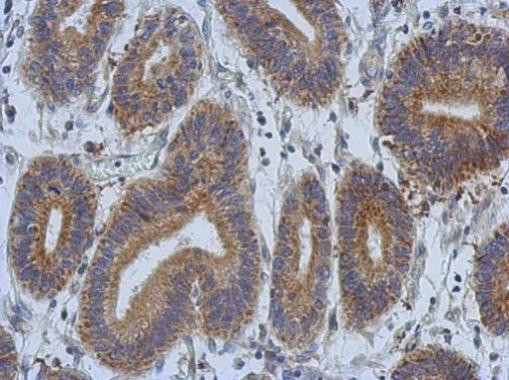
DCBLD2 Antibody in Immunohistochemistry (Paraffin) (IHC (P))

Search
Invitrogen
DCBLD2 Polyclonal Antibody
{{$productOrderCtrl.translations['antibody.pdp.commerceCard.promotion.promotions']}}
{{$productOrderCtrl.translations['antibody.pdp.commerceCard.promotion.viewpromo']}}
{{$productOrderCtrl.translations['antibody.pdp.commerceCard.promotion.promocode']}}: {{promo.promoCode}} {{promo.promoTitle}} {{promo.promoDescription}}. {{$productOrderCtrl.translations['antibody.pdp.commerceCard.promotion.learnmore']}}
产品信息
PA5-28547
种属反应
宿主/亚型
分类
类型
抗原
偶联物
形式
浓度
规格
纯化类型
保存液
内含物
保存条件
运输条件
RRID
产品详细信息
Recommended positive controls: HeLa, HepG2.
Predicted reactivity: Mouse (87%), Rat (87%), Chicken (83%), Bovine (90%).
Store product as a concentrated solution. Centrifuge briefly prior to opening the vial.
靶标信息
This protein is a key enzyme in the catabolic pathway of odd-chain fatty acids, isoleucine, threonine, methionine, and valine. It is probably a dodecamer composed of six biotin-containing alpha subunits and six beta subunits. The protein is located in the mitochondrial matrix. Defects in PCCA are the cause o fpropionic acidemia type I (PA-1) [MIM:606054]. PA-1 is a life-threatening disease characterized by episodic vomiting, lethargy and ketosis, neutropenia, periodic thrombocytopenia, hypogammaglobulinemia, develop-mental retardation, and intolerance to protein.
⚠WARNING: This product can expose you to chemicals including mercury, which is known to the State of California to cause birth defects or other reproductive harm. For more information go to www.P65Warnings.ca.gov.
仅用于科研。不用于诊断过程。未经明确授权不得转售。
生物信息学
蛋白别名: 1700055P21Rik; coagulation factor V/VIII-homology domains protein 1; CUB, LCCL and coagulation factor V/VIII-homology domains protein 1; discoidin; Discoidin, CUB and LCCL domain-containing protein 2; Endothelial and smooth muscle cell-derived neuropilin-like protein; unnamed protein product
基因别名: CLCP1; DCBLD2; ESDN
UniProt ID: (Human) Q96PD2
Entrez Gene ID: (Human) 131566